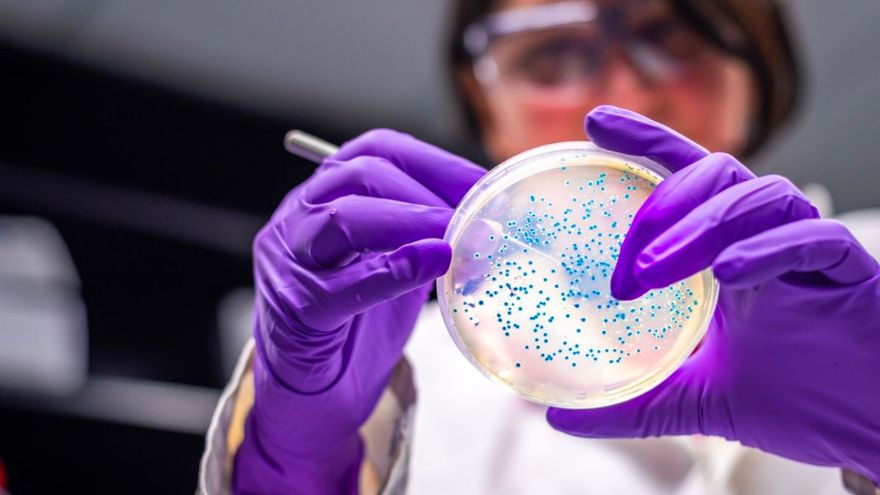

Cuando Los Ángeles Caen
En vivo
El gobierno mexicano suspendió al proveedor de una solución nutricional que se cree está contaminada con una bacteria que habría causado la muerte de más de una decena de niños en hospitales del centro del país, informó este viernes la presidenta Claudia Sheinbaum.
Al menos 13 menores han fallecido en centros médicos del Estado de México, donde a finales de noviembre se detectó un brote de la bacteria Klebsiella oxytoca, posiblemente relacionado con una fórmula que se administra por vía intravenosa, según la secretaría de Salud federal.
La mayoría de los fallecidos eran recién nacidos prematuros, indicó Sheinbaum, quien lamentó los hechos en su habitual rueda de prensa. "Es muy triste que haya ocurrido esto", expresó.
Ocho de las muertes "corresponden a casos confirmados con cultivo positivo a la bacteria Klebsiella oxytoca; uno ha sido descartado y cuatro clasificados como probables", detalló este viernes la secretaría de Salud regional.
Las autoridades sanitarias aseguran que los menores muertos tenían "comorbilidades".
La Comisión Federal para la Protección contra Riesgos Sanitarios (Cofepris) "suspendió por lo pronto a la empresa" que fabrica la solución, señaló Sheinbaum, al reiterar que se investiga si la bacteria estaba presente en los sueros.
La secretaría de Salud federal informó el jueves que "no se descartan" otras hipótesis sobre el origen del brote, que afectó a otros siete niños quienes permanecen bajo observación médica. La entidad mencionó incluso la posibilidad de que la bacteria estuviese en los insumos usados para aplicar la solución.
De acuerdo con las autoridades, la emergencia se presenta en tres hospitales públicos y una clínica privada.
"En el Estado de México está controlada esta situación (...), no se registran más casos en esas cuatro unidades ni en ninguna otra unidad médica del estado", dijo en redes sociales la secretaria de Salud local, Macarena Montoya.
La medida contra la empresa Productos Hospitalarios S.A. incluye la suspensión del registro sanitario que tenía el alimento supuestamente contaminado, cuyo uso fue cancelado el pasado miércoles.
"Los análisis en curso buscan identificar la fuente del brote y se mantiene un monitoreo permanente para descartar posibles brotes en otras entidades" del país, indicó la secretaría de Salud federal en un comunicado.
Montoya explicó que la bacteria se aloja en el tracto digestivo de personas y animales y ataca especialmente a "organismos inmunodebilitados", como fue el caso de los bebés que se encontraban en las unidades de "cuidados intensivos neonatales".
